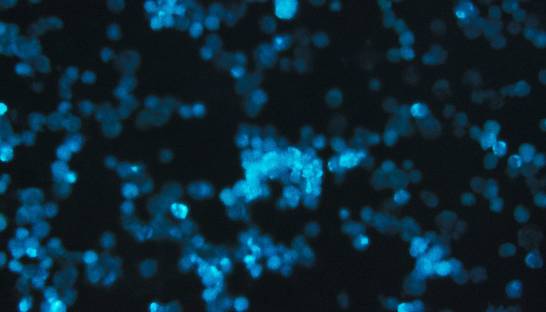
Новый уязвимый механизм: исследователи раскрыли, как остановить развитие лейкемии

- Горячие темы:
- Все для фронта - все про оружие и технику
Лейкемия
Лейкемия связана не только с генами, но и с метаболизмом — важно понять, чем питаются раковые клетки, отмечает онколог Джейн Лисвелд.
Медицина и здоровье
Медицина и здоровье
Люди начали заболевать лейкемией из-за летучих мышей, подхватив от них вирус миллионы лет назад. Этот вирус повлиял на геном наших предков, считают ученые
Открытия
Открытия